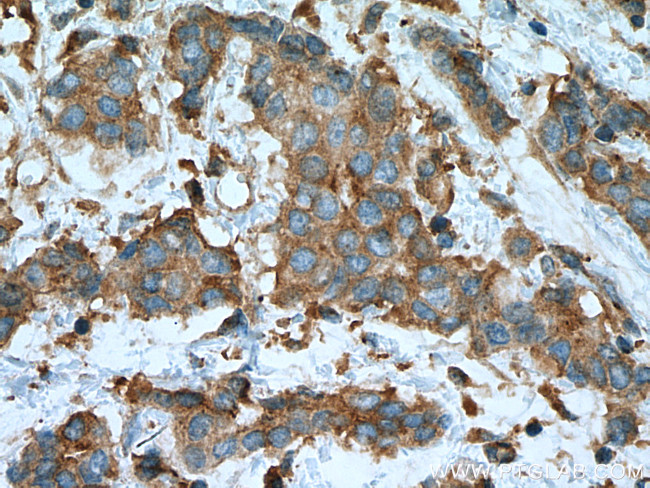
PRKACA Antibody in Immunohistochemistry (Paraffin) (IHC (P))

Search
Proteintech
PRKACA Monoclonal Antibody (4G10D7)
{{$productOrderCtrl.translations['antibody.pdp.commerceCard.promotion.promotions']}}
{{$productOrderCtrl.translations['antibody.pdp.commerceCard.promotion.viewpromo']}}
{{$productOrderCtrl.translations['antibody.pdp.commerceCard.promotion.promocode']}}: {{promo.promoCode}} {{promo.promoTitle}} {{promo.promoDescription}}. {{$productOrderCtrl.translations['antibody.pdp.commerceCard.promotion.learnmore']}}
产品信息
67491-1-IG
种属反应
宿主/亚型
分类
类型
克隆号
抗原
偶联物
形式
浓度
纯化类型
保存液
内含物
保存条件
运输条件
产品详细信息
Aliquoting is unnecessary for -20°C storage.
靶标信息
Protein kinase A (PKA, cAMP-dependent protein kinase) is a key element of a ubiquitous signaling pathway important in the cell cycle, cellular communication, memory formation and behavior. PKA is composed of two catalytic (PKAc; Protein Kinase A catalytic subunit) and two regulatory subunits (PKAr). Upon binding cAMP, the complex dissociates to PKAr dimer and two activated PKAc ser/thr protein kinase catalytic monomers. The released PKAc can translocate into the nucleus and exert a regulatory role in the activation of multiple nuclear hormone receptors. However, PKAc-mediated activation of tonicity-dependent gene expression is cAMP independent. Humans express three types of PKAc subunit - PKAc alpha is present in most human tissues, PKAc beta and gamma are tissue-specific, the later is found in testes.
仅用于科研。不用于诊断过程。未经明确授权不得转售。
篇参考文献 (0)
生物信息学
蛋白别名: C(s); C-alpha-2; C-alpha-S; cAMP-dependent protein kinase catalytic subunit alpha; cAMP-dependent protein kinase catalytic subunit alpha, isoform 1; cAMP-dependent protein kinase catalytic subunit C alpha; MGC102831; MGC48865; PKA; PKA C-alpha; pkac; protein kinase A; protein kinase A catalytic subunit; protein kinase, cAMP-dependent, alpha catalytic subunit; protein kinase, cAMP-dependent, catalytic, alpha; sperm cAMP-dependent protein kinase catalytic subunit
基因别名: Cs-PKA; PKACA; PKCA1; PKCD; PPNAD4; PRKACA
UniProt ID: (Human) P17612, (Mouse) P05132
Entrez Gene ID: (Human) 5566, (Rat) 25636, (Mouse) 18747